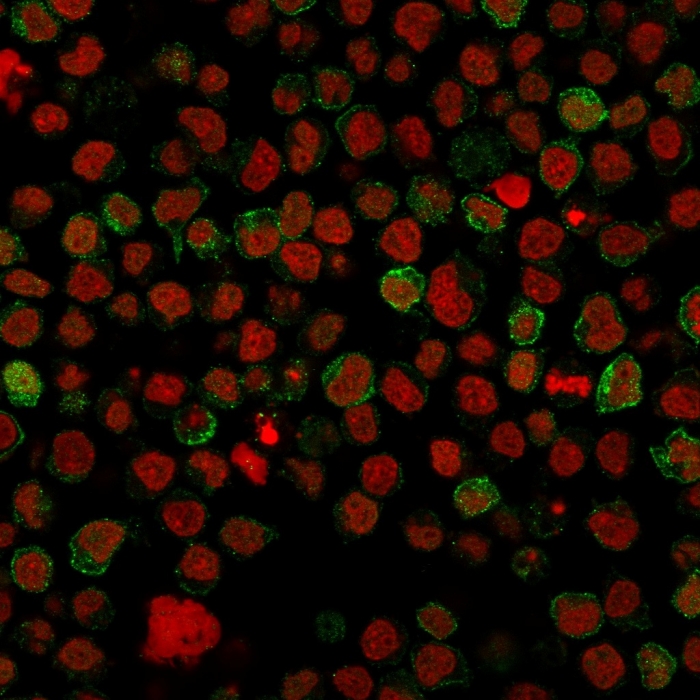

Analysis of Protein Array containing more than 19,000 full-length human proteins using CD22 Mouse Monoclonal Antibody (BLCAM/1796) Z- and S- Score: The Z-score represents the strength of a signal that a monoclonal antibody (MAb) (in combination with a fluorescently-tagged anti-IgG secondary antibody) produces when binding to a particular protein on the HuProtTM array. Z-scores are described in units of standard deviations (SD’s) above the mean value of all signals generated on that array. If targets on HuProtTM are arranged in descending order of the Z-score, the S-score is the difference (also in units of SD’s) between the Z-score. S-score therefore represents the relative target specificity of a MAb to its intended target. A MAb is considered to specific to its intended target, if the MAb has an S-score of at least 2.5. For example, if a MAb binds to protein X with a Z-score of 43 and to protein Y with a Z-score of 14, then the S-score for the binding of that MAb to protein X is equal to 29.

Flow Cytometric Analysis of Ramos cells using CD22 Mouse Monoclonal Antibody (BLCAM/1796) followed by goat anti-Mouse IgG-CF488 (Blue); Isotype Control (Red).
Immunofluorescence staining of paraformaldehyde-fixed Ramos cells with CD22 Mouse Monoclonal Antibody (BLCAM/1796) followed by goat anti-Mouse IgG-CF488 (Green). Nuclei are labeled with Reddot (Red).
Recognizes a protein of 130-140kDa, identified as CD22 (also known as BL-CAM). CD22 expression is restricted to normal and neoplastic B cells and is absent from other haemopoietic cell types. In B-cell ontogeny, CD22 is first expressed in the cytoplasm of pro-B and pre-B cells, and on the surface as B cells mature to become IgD+. It is not expressed by plasma cells, CD22 is found highly expressed in follicular mantle and marginal zone B-cells, and while germinal center B-cells are relatively weak. CD22 is a member of the immunoglobulin superfamily and serves as an adhesion receptor for sialic acid-bearing ligands expressed on erythrocytes and all leukocyte classes. It also associates with tyrosine kinases and play a role in signal transduction and B-cell activation.
There are no reviews yet.